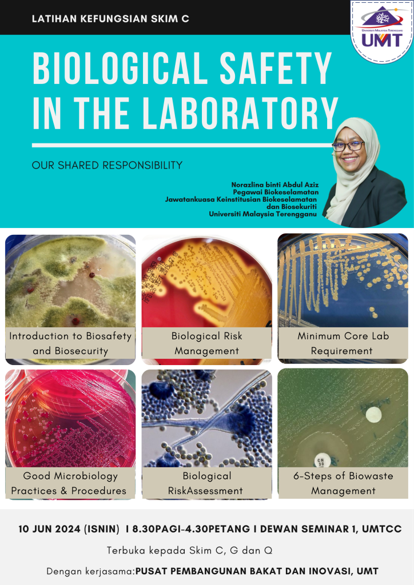

PENGURUSAN BIOKESELAMATAN DAN BIOSEKURITI
Mengurus risiko yang berkaitan dengan agen biologi dan biotoksin yang mungkin boleh membahayakan kesihAatan manusia, alam sekitar atau keselamatan.
Mengawal selia penggunaan agen biologi termasuk organisma yang diubahsuai secara genetik, mikroorganisma dan biotoksin sama ada untuk pelepasan, pengimportan, pengeksportan dan kegunaan terkawal dengan tujuan melindungi kesihatan manusia, tumbuh-tumbuhan dan haiwan, alam sekitar dan kepelbagaian biologi mengikut keperluan Akta Biokeselamatan 2007 dan peraturan-peraturan lain yang berkaitan.
3 Komponen
Tiga komponen utama Pengurusan Biokeselamatan & Biosekuriti:
- Biokeselamatan - Bioteknologi moden
- Biokeselamatan - Mikroorganisma dan biotoksin
- Biosekuriti - Keselamatan Valuable Biological Material dari penyalahgunaan


PKKPU UMT
JAWATANKUASA BIOKESELAMATAN & BIOSEKURITI UMT
01
02
03
PERANAN & TANGGUNG JAWAB
Jawatankuasa Keinstitusian Biokeselamatan dan Biosekuriti Umt
04
PKKPU UMT
PROGRAM BIOKESELAMATAN & BIOSEKURITI

PKKPU UMT




